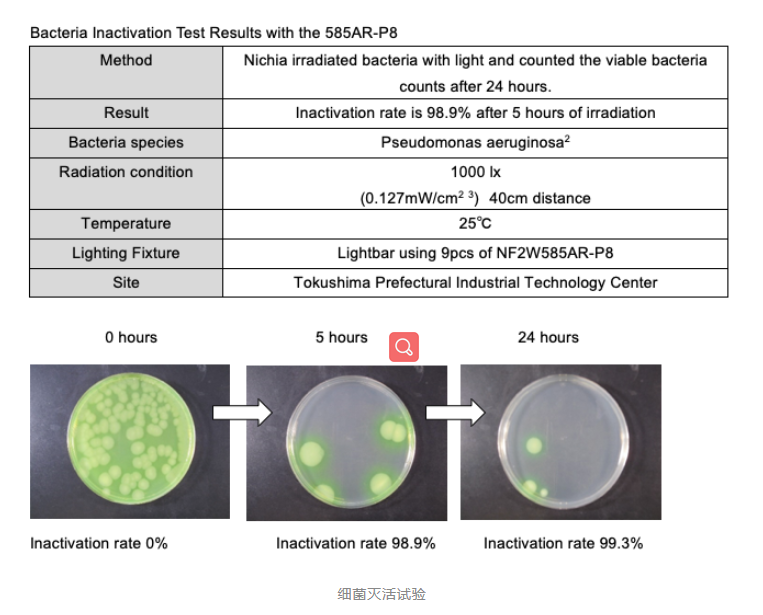
日亚展示用于照明和杀菌双重功能的LED产品

日亚展示用于照明和杀菌双重功能的LED产品
日亚展示用于照明和杀菌双重功能的LED产品
1月25日,Nichia(日亚化学)宣布推出一种新的双功能LED,它既能提供白光又能提供高剂量的能量,用于灭活各种流行细菌。

随着COVID-19的持续蔓延以及对全球的影响,人们对生活各个方面的清洁意识日益增强。该产品既可用于灭活病毒,也适用于我们日常生活环境中的杀菌。引起感染的典型细菌实例是铜绿假单胞菌和金黄色葡萄球菌。另外,引起食物中毒的大肠杆菌也还在世界各地肆虐。
为了协助全球减少这些有害细菌,日亚化学开发了一种新型的白光LED,该LED也能够灭活细菌。该产品型号为NF2W585AR-P8,是一个4.0mm x 3.6mm的LED,是日亚化学通用照明组合的主要产品。
日亚化学表示,UV-C和UV-B波长范围在200nm到380nm之间,尤其是UV-C已被用于消毒。但是,最近已证明可见光在380nm至420nm范围内也具有杀菌作用。NF2W585AR-P8是峰值波长约为405nm的LED解决方案。通过数十年创新,日亚化学领先的荧光粉和模具技术不断完善,能够在单个LED中实现普通白光照明和消毒杀菌之间的平衡。
日亚预计该LED将广泛用于食品工厂、厨房、医院、公共设施和类似应用中的环境卫生维护。(来源:日亚化学网站,中国之光网编译)




















